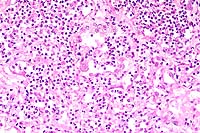

Results
AFIP Wednesday Slide Conference - No. 10
4 November 1998
- Conference Moderator:
Dr. Georgina Miller
NCRR LSS SSB, Bldg. 28A, Room 117
28 Library Drive, MSC 5210
Bethesda, MD 20892-5210
NOTE: Click on images for larger views. Use
browser's "Back" button to return to this page.
Return to WSC Case Menu
- Case I - RT97-1153 (AFIP 2639047)
Signalment: Adult, female, Spontaneous Hypertensive Rat
(SHR).
-
- History: This animal was submitted due to a history
of anorexia and abnormal breathing. It was used in a hypertension
study and was euthanized with CO2.
Gross Pathology: The rat was moderately dehydrated and
thin with diffuse skeletal muscle atrophy and little abdominal
body fat. Moderate dehydration was evident. The urinary bladder
was devoid of urine; testing of residual urine on the mucosa
revealed moderate to high ketonuria and trace glycosuria. The
walls of mesenteric vessels throughout the gastrointestinal tract
were thickened and formed 1-3 mm diameter reddish purple nodules.
Other major organs appeared normal.


- Case 10-1. Gross photos (see paragraph above)
Contributor's Diagnosis and Comments:
- Morphologic Diagnosis: Mesenteric arteries/arterioles
- arteriopathy with smooth muscle hypertrophy and thrombosis.
- Etiologic diagnosis: Hypertensive arteriopathy/arteriolopathy.
-
- The rat had multiple organ abnormalities secondary to vascular
disease, consistent with hypertension. Arteriolar changes in
the myocardium included medial hypertrophy and medial fibrinoid
degeneration. Mesenteric and pancreatic arteries and arterioles
were prominently dilated, tortuous, and had subintimal proliferation
and medial hypertrophy, with mild to variable amounts of chronic
perivascular inflammation. Many of the vessels were partially
to completely occluded by thrombi. There were increased numbers
of blood vessels of varying size within the mesentery. Pulmonary
edema was present, along with increased numbers of alveolar macrophages
and erthyrophagocytosis, consistent with chronic congestive heart
failure. One adrenal gland and a section of small intestine were
infarcted secondary to vascular compromise. Renal abnormalities
included medial hypertrophy and intimal proliferation of arterioles,
multifocal glomerulosclerosis, and associated tubular ectasia
with proteinaceous fluid. The predominant findings in this case
are consistent with vascular disease and related sequelae secondary
to hypertension.
-
- The enlarged and tortuous mesenteric arteries demonstrate
a number of changes associated with hypertension. In some areas,
the endothelial lining appears relatively normal whereas in other
regions, the endothelium is necrotic with fibrin deposition and
thrombi formation. Most of the thickening of the arteries is
in the tunica media, and enlarged myocytes with enlarged nuclei
are clearly seen in the smooth muscle indicating hypertrophy.
In some areas, a discrete border is lacking between the muscle
cells and adventitial fibroblasts. The adventitial layer is distended
due to increased collagen deposition. Hemorrhage and hemosiderin
deposits are present. There is an inflammatory reaction consisting
predominately of neutrophils in both the media and the adventitia.
Affected arterioles are evident in both the muscularis and submucosa
of the intestine. Some arterioles have a narrowed lumen with
characteristic "onion skinning". Based on gross morphology,
the principal differential diagnosis is polyarteritis nodosa,
a generalized immune-complex disease. In rats with polyarteritis,
vascular lesions are commonly found in mesenteric arteries and
their branches, but muscular arteries in any organ may be involved.
Grossly, the arteries are tortuous and often exhibit thrombosis
or occlusion.
-
- The spontaneous hypertensive rat (SHR) was first developed
in 1963 from outbred Wistar Kyoto rats by Okamoto and Aoki to
develop an animal model for hypertension. The strain has been
successful in that 100% of the rats develop spontaneous hypertension.
Long term hypertension is known to cause severe arterial disease
which can result in hemorrhage, infarction and nephrosclerosis.
The arterioles in spontaneous hypertensive rats show a thickening
of the tunica media consistent with periarteritis nodosa, and
the structural adaptation of the vessels occurs in response to
an increased pressure load.
-
- In severe hypertensive animals, arteries progress through
a number of phases based on the age of animal and the degree
of blood pressure elevation. Arteries with a diameter of less
than 300 mm determine pressure resistance. In hypertension, pressure
resistance is elevated, implying a narrowing of vasculature.
The mesenteric artery of SHR has a 16% smaller luminal diameter
and a 49% thicker media than nonhypertensive rats. Blood pressure
increases steadily after 6 weeks of age in SHR, rising from 170
mmHg to around 200 mmHg and finally reaching over 250 mmHg by
death. The arteries go through phases beginning with a prehypertensive
period to eventually irreversible damage. During the prehypertensive
phase, the surface of the internal elastic lamina becomes irregular,
then the elastic lamina is destroyed, and modified medial smooth
muscle cells appear. Finally, the internal and medial elastic
lamina are both completely destroyed and small fragments of the
laminae are all that remain.
-
- Before six weeks of age, mesenteric arterial smooth muscle
cells appear morphologically normal with blood pressure around
170 mmHg. After 6 to 7 weeks, the innermost medial smooth muscle
cells begin to show alterations of shape because of an increase
of cell organelles. The prominent morphological changes include
a marked increase and dilatation of rough endoplasmic reticulum
containing electron-dense material. By around 13 weeks of age,
blood pressure has increased to around 210 mmHg and the smooth
muscle cells of the mesenteric arteries show greater change.
The shape of the smooth muscle cell is irregular and few organelles
are seen in the cytoplasm. The internal elastic lamina and the
medial smooth muscle cells begin to interact via plasma membrane
protrusions from the muscle cells. The shape of the smooth muscle
cell is extremely irregular in the middle layer of the media.
Once blood pressure has increased to over 240 mmHg, the rat has
reached advanced stages of hypertension. This usually occurs
by week 28 and there are marked degenerative and degradative
changes in the smooth muscle cells, especially in the inner media.
Prominent protrusions of the plasma membrane extend to the internal
elastic lamina and elastic fiber becomes fragmented, indicating
destruction of the internal elastic lamina by smooth muscle cells.
Commonly, medial smooth muscle cells will migrate into the subintimal
region. By the final stage of hypertension, the internal elastic
lamina appears fragmented and the media is thickened.
-
- Thickening of the arterial wall in chronic hypertension is
thought to be the result of both hypertrophy and hyperplasia
of the medial smooth muscle cell, although the degree of each
differs based on the type of artery: elastic, muscular, or arteriolar.
For example, both hypertrophy and hyperplasia contribute to wall
thickening in muscular arteries, but arteriolar vessels show
a greater amount of hyperplasia. It has been suggested that hyperplasia
is a very early event which reaches its maximum even while blood
pressure is submaximal. The degree and duration of hypertension
determines which is predominant.
 2x
obj
2x
obj
- Case 10-1. Mesentery. There is medial hypertrophy
and inflammatory infiltrates around the affected vessels. Some
arteries have fibrinoid degeneration and/or thrombi in arterial
lumens. Perivascular mesenteric fat contains high numbers of
inflammatory cells (steatitis).
 20x
obj
20x
obj
- Case 10-1. Mesenteric artery. There is extensive fibrinoid
degeneration of the vessel and moderate perivascular infiltrates
of lymphocytes and macrophages.
-
- AFIP Diagnoses:
- 1. Mesentery, arteries: Arteriopathy, characterized by fibrosis,
medial hypertrophy, fibrinoid change, thrombosis and chronic-active
arteritis, spontaneous hypertensive rat (SHR), rodent.
2. Mesenteric adipose tissue: Steatitis, chronic-active, diffuse,
mild.
-
- Conference Note: The pathogenesis of the vascular
changes occurring in spontaneous hypertensive rats (SHR) has
been well described by the contributor. Interestingly, the anatomical
locations, gross appearance, and histomorphology of the lesions
in SHR are very similar to those of polyarteritis (periarteritis)
nodosa (PAN). As mentioned by the contributor, the vascular lesions
attributed to hypertension in SHR develop early (6 to 7 weeks)
and progress with age. The severity and distribution of affected
arteries is greater in SHR males than in females. Clinically,
polyarteritis nodosa tends to occur in aged rats (reports vary
between 498 and 900 days), and the incidence is higher in males
than females. The lesions of PAN are often found incidentally
at necropsy. PAN is believed to be an immune-mediated disease.
-
- In the absence of history and signalment, differentiating
the histologic changes of PAN and those developing in SHR can
be problematic. The microscopic vascular lesions that occur in
SHR have been characterized and sequenced by the contributor.
PAN is classically described as necrotizing vasculitis and fibrinoid
necrosis affecting small and medium-sized vessels of multiple
organ systems. In the acute phase, the vasculitis is characterized
by transmural infiltration of the vascular wall by high numbers
of neutrophils, eosinophils, and mononuclear cells with fibrinoid
necrosis of the inner half of the vessel. At later stages, the
acute inflammatory infiltrate disappears and is replaced by fibrous
thickening of the vessel wall accompanied by a mononuclear cell
infiltrate13. A characteristic finding in PAN is the presence
of unaffected and severely affected blood vessels within the
same tissues, as well as segmental lesions along individual blood
vessels14. Subjectively, the vascular lesions in PAN seem to
be characterized by higher numbers of inflammatory cells that
are more disruptive to the vessel walls compared to the arterial
changes in SHR.
-
- In this case, in some sections of the small intestine, arterioles
within the lamina propria and tunica muscularis are characterized
by concentric, laminated thickening of the vessel wall, which
narrows or occludes the lumen, consistent with "onion-skinning"
as noted by the contributor. Though hypertension may be a complication
in humans suffering from PAN, the microscopic feature of "onion
skinning" with luminal obliteration in this rat is characteristic
of hyperplastic arteriolosclerosis. Hyperplastic arteriolosclerosis
is more consistent with hypertension than an immune-mediated
etiology.
-
- Contributor: Pathology Unit, Laboratory Sciences Section,
Veterinary Resources Program, NCRR, National Institute of Health,
9000 Rockville Pike, Bethesda, MD 20892.
-
- References:
- 1. Black MJ, et al.: Vascular growth responses in SHR and
WKY during development of renal hypertension. Amer J Hypertension
10:43-50, 1997.
- 2. Dominiczak AF, et al.: Vascular smooth muscle polyploidy
and cardiac hypertrophy in genetic hypertension. Hypertension
27:752-759, 1996.
- 3. McGuffee LJ, Little SA: Tunica media remodeling in mesenteric
arteries of hypertensive rats. Anatomical Record 246:279-292,
1996.
- 4. Dilley RJ, Kanellakis P, Oddie CJ, Bobik A: Vascular hypertrophy
in renal hypertensive spontaneously hypertensive rats. Hypertension
24:8-15, 1994.
- 5. Ganten D, de Jong W: Experimental and genetic models of
hypertension, In: Handbook of Hypertension, vol. 16, Elsevier
Science B.V., Amsterdam, Holland, 1994.
- 6. Ito H: Pathophysiological changes of the membrane system
of the arterial smooth muscle cells. In: Membrane Abnormalities
in Hypertension, Kwan CY ed., vol. 2, pp. 2-21, CRC Press Inc.,
Boca-Raton, Florida, 1989.
- 7. Lee RMKW: In: Blood Vessel Changes in Hypertension: Structure
and Function, vol. 1, pp. 2-17, CRC press Inc., Boca-Raton, Florida,
1989.
- 8. Lee RMKW, Forrest JB, Garfield RE, Daniel EE: Ultrastructural
changes in mesenteric arteries from spontaneously hypertensive
rats. Blood Vessels 20:72-91, 1983.
- 9. Cox, R: Basis for the altered arterial wall mechanics
in the spontaneously hypertensive rat. Hypertension 3:485-495,
1981.
- 10. Andrews EJ, Ward BC, Altman NH: In: Spontaneous Animal
Models of Human Disease, vol. 1, pp. 51-54, Academic Press, New
York, 1979.
- 11. Baker HJ, Lindsey JR, Weisbroth S: In: The Laboratory
Rat: Volume I Biology and Diseases, pp. 63-72, Academic Press,
Inc., New York, 1979.
- 12. Benirschke K, Garner FM, Jones TC: In: Pathology of Laboratory
Animals, vol. 2, pp. 2018-2055, Springer-Verlag New York, Inc.,
New York, 1978.
- 13. Cotran RS, Kumar V, Collins T: Blood vessels. In: Robbins
Pathologic Basis of Disease, 6th ed., pp. 510-522, WB Saunders,
Philadelphia, PA, 1999.
- 14. Snyder PW, et al.: Pathologic features of naturally occurring
juvenile polyarteritis in beagle dogs. Vet Path 32:337-345, 1995.
- 15. Anver MR, Cohen BJ: Lesions associated with aging. In:
The Laboratory Rat Volume I Biology and Disease, Baker HJ, Lindsey
JR, Weisbroth SH eds., pp. 383-384, Academic Press Inc., New
York, New York, 1979.
- 16. Wexler BC, McMurtry JP, Iams SG: Histopathologic changes
in male vs female spontaneously hypertensive rats. J Gerontol
36:514-519, 1981.
- 17. Suzuki T, Oboshi S, Sato R: Periarteritis nodosa in spontaneously
hypertensive rats - incidence and distribution. Acta Pathol Jpn
29:697-703, 1979.
-
- Case II - Vn-72-98 (AFIP 2642410)
-
- Signalment: One-year-old, male, guinea pig (Cavia
porcellus).
-
- History: This is one of five guinea-pigs which were
raised as pets in a household. The owner brought the animal to
the attention of a veterinary practitioner because of "growths"
on its ears that had been present for almost five months. The
animal was otherwise normal. A decision was made to euthanatize
the guinea-pig, and it was submitted to our lab for necropsy.
Gross Pathology: The pinna of the right ear was irregularly
swollen and alopecic, and the overlying skin of the dorsum of
the pinna was bright red, ulcerated and covered by crusts (color
transparency). At the base of the left ear there was a gray,
firm, alopecic nodule measuring 1.5 cm in diameter. Other organs
were unremarkable.

- Case 10-2. Gross photo (see description above)
-
- Laboratory Results: None.
-
- Contributor's Diagnosis and Comments: Skin of the
ear: Dermatitis and panniculitis, granulomatous, focally extensive,
moderate to severe, with intracytoplasmic protozoal amastigotes
within macrophages, etiology consistent with Leishmania sp. (cutaneous
leishmaniasis), guinea-pig (Cavia porcellus).
-
- Leishmaniasis is a zoonotic disease caused by many pathogenic
species and variously named subspecies of the genus Leishmania
(order Kinetoplastida, family Trypanosomatidae). Differentiation
among species cannot be made based only on their morphological
aspects in tissue sections. Differentiation is based on clinical
signs and pathological changes, morphological aspects and behavior
of the parasite, and on specific laboratory tests (e.g., serology,
immunohistochemistry, indirect immunofluorescence).
-
- Leishmania spp. occur in two parasite forms. The intracellular
amastigotes (found in parasitophorous vacuoles within macrophages
of the vertebrate host) and the promastigote (found predominantly
in the sandfly vector). The amastigotes are spherical, 2.5 to
5 mm, have a prominent, eccentric nucleus, and a transversely
oriented kinetoplast.
-
- Diseases caused by Leishmania sp. are transmitted by hematophagous
sandflies which include the genera Lutzomyia sp. (in the New
World) and Phlebotomus (in the Old World). When the insect vector
takes a blood meal, it becomes infected by ingestion of infected
macrophages containing amastigotes. These are released from the
macrophages in the midgut of the insect and transform into promastigotes
(10-20 mm in length). The insect vectors then take another blood
meal and, in doing so, infect the next mammalian host. There
is usually a primary reservoir host for a given Leishmania species
in a particular area where the parasite is maintained in a cycle
between the insect and the vertebrate host.
-
- Clinically and epidemiologically, the disease can be divided
into three main forms caused by different species of Leishmania.
Dermal cutaneous leishmaniasis (L. tropica, L. major), visceral
leishmaniasis (L. donovani), and mucocutaneous leishmaniasis
(L. braziliensis, L. mexicana). The lesions of the case described
here are restricted to the dermis and subcutis and are characterized
by marked proliferation of epithelioid macrophages and moderate
amounts of fibrovascular tissue. Most of these macrophages contain
phagocytized amastigotes with morphology consistent with Leishmania
sp. The large numbers of parasites observed in these sections,
although not a consistent finding in leishmaniasis, has been
described previously.
-
- Histoplasmosis, toxoplasmosis, blastomycosis, and trypanosomiasis
should be considered in the differential diagnosis. A kinetoplast
and a small nucleus can be identified in Leishmania organisms
in tissue sections. These structures are absent in the causative
organisms of the first three diseases. The tissue phase of Trypanosoma
cruzi has a kinetoplast, but the distribution and type of lesions
in trypanosomiasis (Chagas disease) differ from those found in
leishmaniasis.
 4x obj
4x obj
- Case 10-2. Ear. The dermis is expanded by large numbers
of macrophages and lymphocytes.
 40x
obj, Giemsa
40x
obj, Giemsa
- Case 10-2. Leishmanial amastigotes appear as oval
3-5u basophilic structures surrounded by clear halos.
-
- AFIP Diagnosis: Haired skin, auricular: Dermatitis,
histiocytic and lymphoplasmacytic, diffuse, severe, with ulceration,
serocellular and hemorrhagic crust, and numerous intrahistiocytic
protozoal amastigotes, guinea pig (Cavia porcellus), rodent.
-
- Conference Note: Most conference participants preferred
the morphologic diagnosis of histiocytic and lymphoplasmacytic
dermatitis rather than granulomatous dermatitis because of the
lack of multinucleate macrophages and activated epithelioid macrophages
(macrophages with abundant eosinophilic cytoplasm and large,
vesiculate nuclei containing prominent nucleoli), the histologic
hallmarks of granulomatous inflammation.
-
- Leishmania amastigotes are the only protozoa that survive
and replicate in the macrophage phagolysosome. After phagocytosis
of the promastigotes by macrophages, the acidity in the phagolysosome
induces them to transform into amastigotes. The amastigotes are
protected from lysosomal acid by a proton-transporting ATP-ase
which maintains the intracellular pH of the parasite at 6.5.
Additionally, leishmanial organisms have on their surface two
glycoconjugates which appear to be important virulence factors.
Lipophosphoglycans are glycolipids that form a dense glycocalyx
and bind to C3b and iC3b. Organisms resist lysis by complement
C5-C9, and are phagocytosed by macrophages through complement
receptors CR1 (LFA-1) and CR3 (Mac-1)6. Lipophosphoglycans may
also serve to protect amastigotes by inhibiting lysosomal enzymes
and scavenging oxygen free radicals. The second glycoconjugate,
gp63, is a zinc-dependent metalloproteinase that cleaves complement
and some lysosomal enzymes.
-
- Conference participants briefly discussed the predisposition
for development of cutaneous lesions on the ears in several reports
of leishmaniasis in various animals. The skin of the face and
the ears are most exposed to the environment, and may predispose
these areas on hosts to inoculation by the sandfly vector. Another
explanation for the predilection of lesions at these anatomical
sites may be related to temperature. Leishmania sp. that cause
visceral disease grow at 37°C in vitro, while those that
cause mucocutaneous disease, grow only at 34°C6. The tips
of the ears are probably cooler than other areas of skin.
-
- Like the contributor, participants considered a similar differential
diagnosis for this cutaneous lesion based upon the character
of the inflammation, the presence of intrahistiocytic organisms,
and organism morphology. In tissue sections, leishmanial amastigotes
are spherical to ovoid and measure 2 by 5mm. Each amastigote
contains a round, eccentric nucleus and rod-shaped kinetoplast
that lies perpendicular to the nucleus; both structures are basophilic
in hematoxylin and eosin stained sections; in Giemsa-stained
sections the nucleus is red.
-
- In contrast, the kinetoplast of Trypanosoma cruzi amastigotes
is found parallel to the nucleus, and is larger and more basophilic
than that of Leishmania. Histoplasma organisms, also typically
found within macrophages, are similar in size to Leishmania and
may illicit an intense histiocytic to granulomatous response;
however, the yeasts lack a kinetoplast and are stained by the
PAS and GMS methods. Blastomyces dermatitidis, usually found
as a spherical yeast measuring between 7-15mm with a double-contoured
cell wall, is found both within macrophages and extracellularly;
the organism is characterized by single, broad base budding and
stains with GMS and PAS. Toxoplasma gondii and Neospora caninum
tachyzoites may be round, oval, or crescent-shaped, measure between
4 to 6mm, contain a basophilic nucleus, and lack a kinetoplast.
Tachyzoites may be found within a variety of host cells, including
leukocytes, endothelial cells, stromal cells, and epithelial
cells.
-
- Contributor: Universidade Federal de Santa Maria,
Departamento de Patologia, 97105-900, Santa Maria RS, Brazil.
-
- References:
- 1. Jones TC, Hunt RD, King NW: Diseases caused by protozoa.
In: Veterinary Pathology, 6th ed., pp. 549-600, Williams and
Wilkins, Baltimore, 1997.
- 2. Ramos-Vara JA, Ortiz-Santiago B, Segalès J, Dunstan
RW: Cutaneous leishmaniasis in two horses. Vet Pathol 33:731-734,
1996.
- 3. van der Lugt JJ, Stewart CG: Leishmaniasis. In: Infectious
Diseases of Livestock with Special Reference to Southern Africa,
Coetzer JAW, Thomson GR, Tustin RC eds., vol.1, pp. 269-272,
Oxford, Cape Town, South Africa, 1994.
- 4. Gardiner CH, Fayer R, Dubey JP: Sarcomastigophora. In:
An Atlas of Protozoal Parasites in Animal Tissues, 2nd ed., pp.
3-10, Armed Forces Institute of Pathology, Washington DC, 1998.
- 5. Gardiner CH, Fayer R, Dubey JP: Apicomplexa. In: An Atlas
of Protozoal Parasites in Animal Tissues, 2nd ed., pp. 53-60,
Armed Forces Institute of Pathology, Washington DC, 1998.
- 6. Cotran RS, Kumar V, Collins T: Infectious diseases. In:
Robbins Pathologic Basis of Disease, 6th ed., pp. 391-392, WB
Saunders, Philadelphia, PA, 1999.
- 7. Yager JA, Wilcock BP: Nodular and/or diffuse dermatitis.
In: Color Atlas of Surgical Pathology of the Dog and Cat, pp.
119-130, Wolfe Publishing, London, England, 1994.
-
-
- Case III - 97N0525 (AFIP 2642200)
-
- Signalment: 2½-year-old, Walker hound, male,
canine.
-
- History: This dog was one of a litter of three puppies
raised together as a hunting group. Animals were kept in an outdoor
kennel year round and were current on vaccinations. Each animal
developed ulcerated hind limb digital pads and was treated for
bacterial infections with systemic antibiotics, local debridement,
and hydrotherapy. This dog had a digit amputated due to the severity
of the ulceration that had progressed to gangrene. One of the
other littermates died and was not necropsied. This dog became
severely dyspneic and anorexic and was presented in lateral recumbency.
The dog died despite fluid therapy, intravenous broad-spectrum
antibiotics, and steroids. The surviving dog seemed to improve
with systemic gentamycin and topical therapy of the toes.
-
- Gross Pathology: A 25 pound (11.3 kg), adult, male,
black and tan Walker hound was presented for necropsy. The dog
was in adequate nutritional status and had mild autolysis. The
right rear footpad had sloughed, and the caudal tarsus had a
two centimeter diameter ulcer of the plantar surface above the
footpad. The toenail of the second digit was missing. The liver
was enlarged and had an accentuated lobular pattern. Both kidneys
had several wedge-shaped depressions characteristic of chronic
infarcts. The right cranial and caudal lung lobe vessels each
contained 15 or more nematodes typical of Dirofilaria immitis.
The main pulmonary artery had more than 15 adult worms. The left
and right cardiac ventricles were enlarged; the chambers were
dilated and the free walls were thickened. The mitral and tricuspid
valve leaflets were thickened and irregular. The femoral, saphenous,
and tarsal veins and arteries contained adult nematodes. All
lymph nodes seen were enlarged and dark red. Both testes were
firm, small, and intraabdominal. The prostate gland was very
small.

- Case 10-3. Tarsal region. The metatarsal pad is necrotic
and covered with a brown exudate which contains a pale tan nematode
parasite.
-
- Laboratory Results: A mixed population of bacteria
grew from a culture of the right hind footpad.
-
- Contributor's Diagnosis and Comments: Tarsal and carpal
vessels: Inflammation, perivascular, focal, mild, chronic, with
adult filarial nematodes in perivascular tissue and in arteries.
-
- Etiology: Dirofilaria immitis.
- It is unusual even in endemic areas to see Dirofilaria immitis
adults in the systemic arteries and in tissues. This dog and
its littermates had never received heartworm preventive treatment
and had overwhelming infections. The adult heartworms in the
arteries of the distal limbs led to inflammation and blockage
of the vessels with impedance of blood flow. This created the
appropriate environment for gangrene.
 2x
obj
2x
obj 10x
obj
10x
obj
- Case 10-3. Fibroelastic artery. There are cross sections
of two nematodes within a large artery. The 10x view shows two
empty uteri and a smaller gut in the pseudocoelom. There is a
coelomyarian musculature on either side of two large flattened
lateral cords (top & bottom center). Portions of a fibrin
thrombus and the arterial wall are in the lower right corner.
-
- AFIP Diagnosis: Subcutis, fibroelastic arteries: Arteritis,
chronic-active, focally extensive, moderate, with periarteritis,
fibrin thrombus, and intraluminal adult nematode parasite, Walker
hound, canine, etiology consistent with Dirofilaria immitis.
-
- Conference Note: This case was studied in consultation
with Dr. C.H. Gardiner, parasitology consultant to the Department
of Veterinary Pathology. Morphologically, this adult nematode
parasite is characterized by a cuticle with lateral internal
ridges that project into hypodermal chords, coelomyarian, polymyarian
musculature which is divided by the flattened hypodermal chords,
and a pseudocoelom which contains an intestine with small lumen
and two reproductive tubes (uteri). In some sections, the uteri
contain sperm, indicating that copulation had occurred.
-
- Aberrantly located adult heartworms have been infrequently
reported in dogs since the middle of the 19th century. Reported
sites include the eyes, subcutaneous interdigital cysts, intramuscular
cysts and abscesses, peritoneal cavity, bronchioles, in a salivary
gland mucocele, and the central nervous system including the
lateral ventricles and the epidural space. Clinical signs observed
in dogs with systemic arterial dirofilariasis include lameness,
weakness, poor peripheral perfusion, paresthesia of the hindlimbs,
and ischemic necrosis of tissues such as muscle and digits due
to thromboembolic disease.
-
- Systemic arterial dirofilariasis is an uncommon condition,
and the pathogenesis is not completely understood. In some reported
cases, migration of parasites was thought to have occurred from
the right ventricle through an identified ventricular septal
defect, patent ductus arterious, or a patent foramen ovale after
development of high right heart pressures and pulmonary hypertension.
In other cases, no congenital cardiovascular defect was identified
during necropsy. In these cases, the condition may have occurred
due to aberrant migration or development of L5 heartworms within
the systemic arterial circulation. While the mechanism of systemic
arterial dirofilariasis is not understood, the presence of adult
worms in the abdominal aorta may manifest as thromboembolic disease
with subsequent infarcts in the spleen, kidneys, liver, and stomach
resulting in multiple acute organ failure and/or ischemic muscle
or digital necrosis.
-
- Based on morphology and location of a nematode within an
artery, Angiostrongylus sp. was also considered in the differential
diagnosis. The adults of Angiostrongylus vasorum reside in the
pulmonary arteries and right ventricle of dogs and foxes and
incite a proliferative endarteritis similar to that in dirofilariasis.
Angiostrongylus spp. are metastrongylid parasites characterized
by a large intestine with few multinucleate cells and a microvillar
border, in contrast to the small, indistinct intestine of Dirofilaria.
The presence of eggs in the uterus of adult angiostrongylidae
is another distinguishing morphologic feature.
-
- Conference participants also discussed several other intravascular
metazoan parasites known to occur in animals. Schistosoma sp.
(blood flukes) are trematodes that predominately affect portal
and mesenteric vessels in various animal species. The fourth
stage larvae of the nematode Strongylus vulgaris primarily affects
the mesenteric arteries of horses. Elaeophora schneideri, the
arterial worm of deer and sheep, is a nematode primarily affecting
the carotid arteries and is the cause of the clinical entity
known as sorehead.
-
- Contributor: Louisiana State University, School of
Veterinary Medicine, Baton Rouge, LA 70803.
-
- References:
- 1. Frank J, et al.: Systemic arterial dirofilariasis in five
dogs. J Vet Intern Med 11:189-194, 1997.
- 2. Goggin G, et al.: Ultrasonographic identification of Dirofilaria
immitis in the aorta and liver of a dog. J Amer Vet Med Assoc
210:1635-1637, 1997.
- 3. Henry CJ: Salivary mucocele associated with dirofilariasis
in a dog. J Amer Vet Med Assoc 200:1965-1966, 1992.
- 4. Slonka FS, Castleman W, Krum S: Adult heartworms in the
arteries and veins of a dog. J Amer Vet Med Assoc 170:717-719,
1977.
- 5. Chitwood M, Lichtenfels JR: Identification of parasitic
metazoa in tissue sections. In: Experimental Parasitology, 32:458-460
and 491-495, Academic Press, 1972.
- 6. Davidson WR, Nettles VF: White-tailed deer. In: Field
Manual of Wildlife Diseases in the Southeastern United States,
2nd ed., Southeastern Cooperative Wildlife Disease Study, University
of Georgia, GA, 1997.
-
- Case IV - 38613 (AFIP 2643569)
-
- Signalment: Nine-year-old, female, pygmy chimpanzee
(Pan paniscus).
-
- History: Several animals in the pygmy chimpanzee group
exhibited signs of upper respiratory tract infection including
nasal discharge, coughing, sneezing, tachypnea and open-mouth
breathing. The animals were also lethargic and inappetent. Animals
were treated symptomatically (expectorant, non-steroidal antiinflammatory
drug). This adult female was found dead on the morning of the
fourth day. She was three weeks post-parturient.
-
- Gross Pathology: Abundant mucopurulent to sanguineous
fluid flowed from the nostrils bilaterally. The nasal mucosa
was reddened. Bilaterally, vocal sacs contained abundant mucopurulent
to hemorrhagic exudate. A moderate amount of white froth partially
filled the trachea and bronchi. Dorsal-caudal lung lobes were
firm and discolored purple. Cranioventral lobes and the periphery
of the dorsal lobes were slightly firm and discolored. The cut
surfaces of the lungs were dry and dense. Sections of lung from
all areas were observed to float in formalin. Tracheobronchial
lymph nodes were mildly enlarged. The cervix was closed. The
uterus was mildly enlarged, had a slightly reddened mucosa, and
contained 3 to 5 milliliters of dark red/brown fluid, consistent
with post-partum status. Milk was easily expressed from both
teats.
-
- Laboratory Results:
-
- 1. Bacterial cultures:
a. Aerobic culture of lung: 1+ Streptococcus viridans group,
1+ Staphylococcus aureus.
b. Aerobic culture of vocal sac: 3+ Staphylococcus aureus.
c. Aerobic culture of heart blood: Streptococcus viridans group,
Enterobacter cloacae, non-hemolytic streptococcus, Staphylococcus
aureus, Streptococcus viridans group II, beta-hemolytic streptococci
group B.
d. Anaerobic culture of lung and vocal sac: No growth.
e. Fungal culture of lung and vocal sac: No growth.
f. Virus isolation lung and nasal exudate (Simian Diagnostic
Lab, San Antonio, TX): No virus isolated.
-
- 2. Cytology:
a. Nasal exudate: Mucopurulent exudate with numerous extra- and
intracellular gram-positive cocci.
b. Air sac: Purulent exudate, sloughed columnar epithelial cells
and extra- and intracellular gram-positive cocci.
c. Lung: Abundant neutrophils and erythrocytes, with fewer macrophages
and epithelial cells. Macrophages tend to have abundant foamy
cytoplasm. Epithelial cells have enlarged nuclei, and there are
occasional binucleated forms. Low numbers of intracellular gram-positive
cocci and occasional large extracellular gram-positive rods are
detected.
d. Uterus: Abundant erythrocytes with low to moderate numbers
of foamy macrophages. Small amounts of pigment (hemosiderin)
and degenerate neutrophils.
-
- 3. Immunofluorescence (direct or indirect IFA) of
nasal epithelial scraping (Rhinoprobe, University of San Diego
Medical Center):
a. Positive for respiratory syncytial virus.
b. Negative for parainfluenza 1, 2, 3; adenovirus; influenza
A and B.
- 4. Immunohistochemistry of lung (R. C. Hackman, Fred Hutchinson
Cancer Research Center): Positive for respiratory syncytial virus.
-
- Contributor's Diagnoses and Comments:
- 1. Lungs: Severe, diffuse, subacute, suppurative bronchoalveolar
pneumonia with type 2 pneumocyte hyperplasia, hypertrophy and
syncytial cell formation.
2. Lung: Mild, multifocal, chronic acariasis (not present in
all sections).
- Etiology: Respiratory Syncytial Virus with secondary
bacterial infection (gram-positive cocci).
-
- Syncytial cell formation in alveolar epithelium with degeneration
and necrosis of bronchiolar and, to a lesser extent, bronchial
epithelium are characteristic of respiratory syncytial virus
(RSV) infection. Positive immunofluorescence and immunohistochemistry
confirmed the diagnosis of RSV infection. The marked suppurative
nature of the lesion in this case may be due to secondary bacterial
infection, though neutrophils may be a prominent component of
RSV pneumonia.
-
- RSV infection is a common cause of morbidity in human infants
and children. Mortality is uncommon and generally occurs in children
with underlying pulmonary, cardiac or immunosuppressive disease.
Disease in adult humans is usually limited to mild cold symptoms.
Adult fatality is rare unless complicated by immunosuppression
or general debilitation (old age). Although it is common knowledge
that chimpanzees and a few other primate species are susceptible
to RSV infection, there are very few reports or descriptions
of naturally acquired RSV pneumonia in the literature.
 2x
obj
2x
obj
- Case 10-4. Lung. Bronchointerstitial pneumonia. A
suppurative exudate fills many alveoli.
 20x
obj
20x
obj
- Case 10-4. Higher magnification demonstrates type
II pneumocyte hyperplasia, syncytial giant cells, and suppurative
alveolar exudate.
-
- AFIP Diagnosis: Lung: Pneumonia, broncho-interstitial,
acute to subacute, diffuse, severe, with type II pneumocyte hyperplasia,
edema, syncytial cells, and cocci, pygmy chimpanzee (Pan paniscus),
nonhuman primate.
-
- Note: Some sections contain lung mites.
-
- Conference Note: Some conference participants identified
rare arthropod parasites within bronchioles. The morphology of
these lung mites is consistent with Pneumonyssus sp. Cocci are
gram-positive by the Brown and Brenn staining method.
-
- Respiratory syncytial viruses (RSV) are best known as causes
of respiratory disease in humans, other primates, and cattle
(bovine RSV). RSV is a single-stranded, encapsulated, RNA virus
that matures by budding through the cytoplasmic membrane. It
is classified as a pneumovirus (subfamily pneumovirinae) in the
family Paramyxoviridae. The genus pneumovirus also contains a
virus that causes pneumonia in mice, though it is antigenically
unrelated to RSV in humans or cattle. The other subfamily of
the Paramyxoviridae, paramyxovirinae, includes paramyxovirus
(parainfluenza 1, 2 , and 3, equine paramyxovirus, snake paramyxovirus),
morbillivirus (measles, canine distemper, rinderpest, phocine
distemper, cetacean morbillivirus), and rubulavirus (velogenic
viscerotropic Newcastle disease).
-
- In nonhuman primates, RSV was first isolated from a chimpanzee
with respiratory disease and called chimpanzee coryza agent (coryza
meaning inflammation with discharge from the nasal mucosa). Viral
pneumonias may predispose animals to secondary pulmonary bacterial
infection by compromising host defense mechanisms, and RSV infection
likely predisposed this animal to infection by the gram-positive
cocci.
-
- Other potential causes of viral respiratory disease in nonhuman
primates include adenovirus, herpesvirus, orthomyxovirus (influenza),
paramyxovirus (parainfluenza), picornavirus, and morbillivirus
(measles). Conference participants particularly considered measles
virus due to the similarity in microscopic findings to RSV. Both
viral pneumonias may cause type II pneumocyte hyperplasia, syncytial
cell formation, and eosinophilic intracytoplasmic and intranuclear
inclusions. While RSV infection is almost always limited to the
respiratory tract, measles virus often manifests with a concurrent
maculopapular rash and erythema, especially on the face. Other
systemic features of measles virus infection include white, necrotic
foci on the gingiva and tongue, generalized lymphadenopathy,
and syncytial cells and inclusions in various organs including
the liver, lymph nodes, intestines, salivary glands, and lungs.
-
- Contributor: Department of Pathology, Zoological Society
of San Diego, P.O. Box 120551, San Diego, CA 92112-0551.
-
- References:
- 1. Clarke CJ, et al.: Respiratory syncytial virus-associated
bronchopneumonia in a young chimpanzee. J Comp Path 110:207-212,
1994.
- 2. Kalter SS, Heberling RL: Primate viral diseases in perspective.
J Med Primatol 19:519-535, 1990.
- 3. Miller RR: Viral infections of the respiratory tract.
In: Pathology of the Lung, Thurlbeck WM, Churg AM eds., Theime
Medical Publishers Inc., New York, 1995.
- 4. Sedgwick CJ, Robinson PT, Lochner FK: Zoonoses: A zoo's
concern. J Amer Vet Med Assoc 167:828-829, 1975.
- 5. Cotran RS, Kumar V, Collins T: Infectious diseases. In:
Robbins Pathologic Basis of Disease, 6th ed., pp. 340-341, WB
Saunders, Philadelphia, PA, 1999.
- 6. Miller, MJ: Viral taxonomy. In: Clinical Infectious Diseases
25:18-20, UCLA Medical Center, Los Angeles, CA, 1997.
- 7. Jones TC, Hunt RD, King NW: Diseases caused by viruses.
In: Veterinary Pathology, 6th ed., pp. 310-322, Williams &
Wilkins, Baltimore, MD, 1997.
-
- Ed Stevens, DVM
Captain, United States Army
Registry of Veterinary Pathology*
Department of Veterinary Pathology
Armed Forces Institute of Pathology
(202)782-2615; DSN: 662-2615
Internet: STEVENSE@afip.osd.mil
-
- * The American Veterinary Medical Association and the American
College of Veterinary Pathologists are co-sponsors of the Registry
of Veterinary Pathology. The C.L. Davis Foundation also provides
substantial support for the Registry.
- Return to WSC Case Menu


 2x
obj
2x
obj
 20x
obj
20x
obj

 4x obj
4x obj
 40x
obj, Giemsa
40x
obj, Giemsa

 2x
obj
2x
obj 10x
obj
10x
obj
 2x
obj
2x
obj
20x
obj
20x
obj